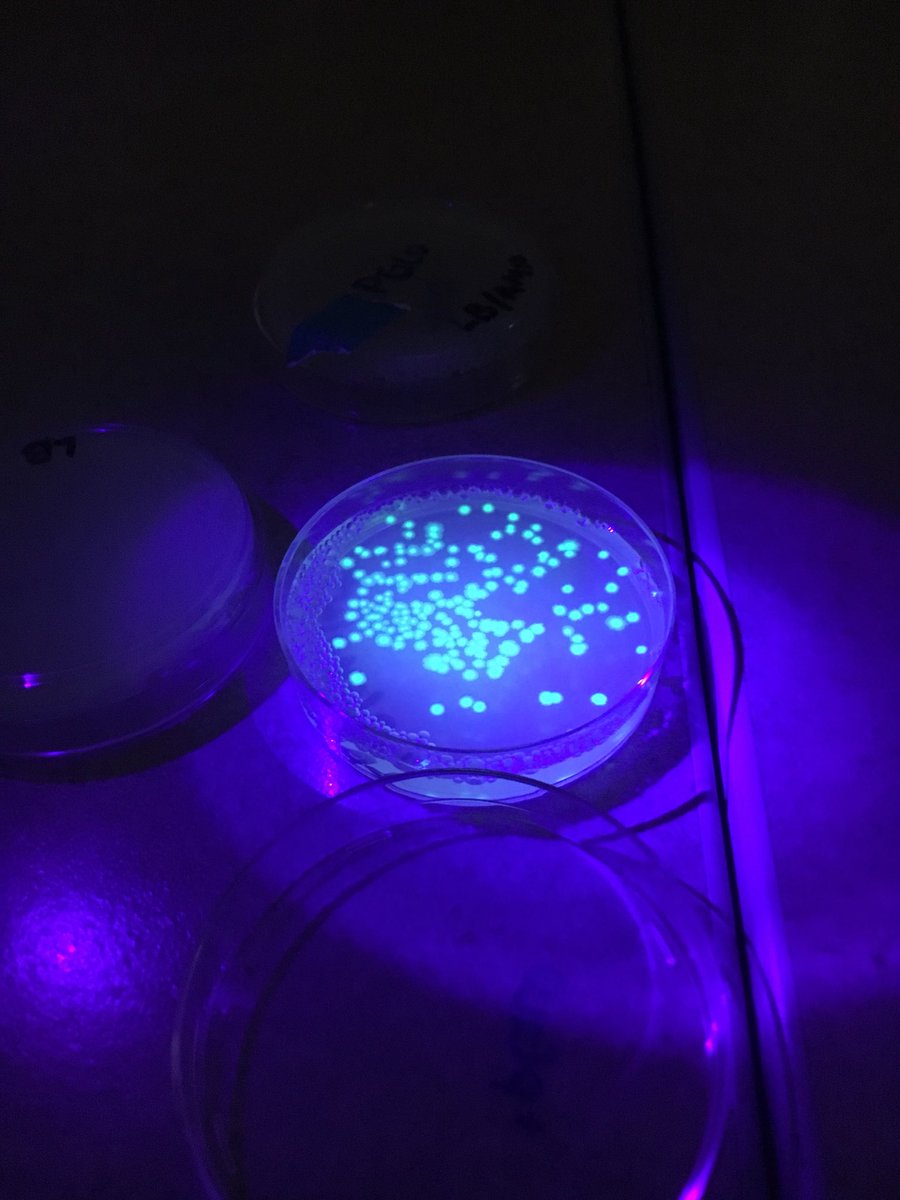

Jamie Gilbert
@jmglbrt
Running through life 1 mile at a time as a high school biology teacher and mother.
ID: 773623974
22-08-2012 13:01:54
658 Tweet
123 Followers
381 Following


We have the best volunteers! OOHS Interact Club







Invented by Dr. Laura Pettler using straws and lasers #oxygencrime #realbiologists #mightygirl gokaleido.net

Back extrapolation using fiber optic dowel rods and lasers. Dr. Laura Pettler #oxygencrime #mightygirl